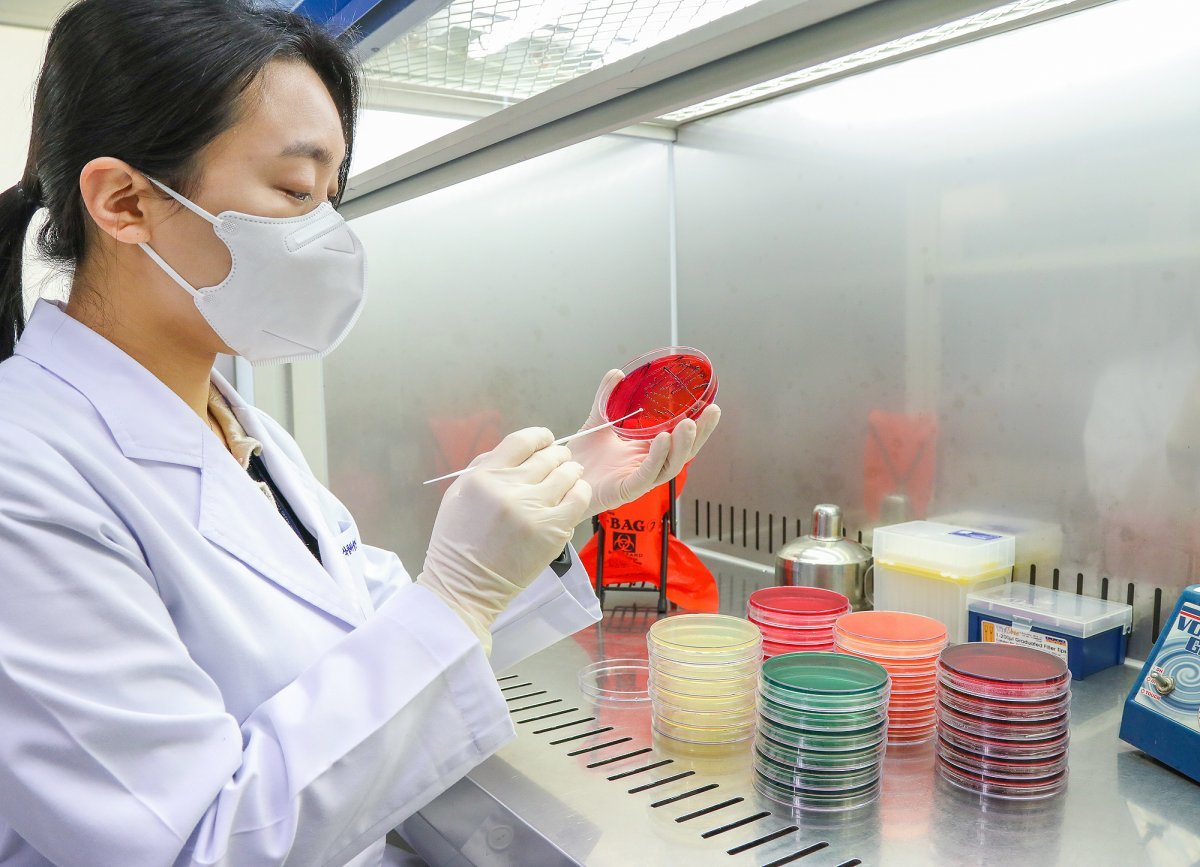

음식물 쓰레기통 위에서 돈가스? 위생 논란 식당, 어디까지 문제인가? 🍴
최근 서울의 한 음식점에서 촬영된 사진이 온라인에서 큰 논란을 일으켰습니다. 🍽️
외국인 종업원이 음식물 쓰레기통 위에서 돈가스를 썰어 제공하는 모습이 공개되면서 소비자들의 분노를 사고 있는데요.

위생과 신뢰가 생명인 외식업에서, 과연 이 행동은 어떤 결과를 초래할까요?
이번 사건을 통해 식품위생의 중요성과 이를 개선하기 위한 방안을 살펴보겠습니다.
1. 사건의 전말: 음식물 쓰레기통 위 돈가스 조리? 😱
(1) 논란의 사진
네이버 카페에 한 배달업 종사자가 올린 사진이 발단이었습니다. 사진에는 음식물 쓰레기통 위에 놓인 접시에서 돈가스를 자르는 종업원의 모습이 담겼습니다.
글쓴이는 "이런 상황에서 음식을 먹었다고 생각하니 비위가 상한다"며 신고 여부를 고민 중이라고 전했습니다.
(2) 소비자 반응
"이건 명백한 위생법 위반이다. 신고해야 한다."
"겉으로 멀쩡해 보이는 가게도 내부 사정은 알 수 없다."
"식품위생법을 철저히 적용해야 한다."

2. 식품위생법의 적용과 처벌 🚨
(1) 식품위생법 규정
식품위생법에 따르면, 음식물은 청결한 환경에서 조리되어야 하며, 작업장은 항상 위생적으로 관리해야 합니다.
이를 어길 경우 과태료가 부과되며, 반복 위반 시 처벌 강도가 증가합니다.
1차 위반: 과태료 50~100만 원
2차 위반: 200만 원
3차 위반 이상: 300만 원
(2) 위생 문제의 위험성
음식물 쓰레기통 위에서 음식을 다루는 행위는 병원성 미생물에 의한 오염 가능성을 높입니다. 이는 식중독, 바이러스 감염 등 소비자의 건강을 위협하는 결과를 초래할 수 있습니다.
3. 외식업 위생 개선 방안 🔍
(1) 사업주와 종업원의 위생 교육
모든 종업원은 식품위생법에 대한 정기적인 교육을 받아야 합니다.
청결한 조리 환경을 유지하기 위한 내부 점검 시스템을 마련해야 합니다.
(2) 소비자의 역할
위생 상태가 의심스러운 식당은 관할 보건소에 신고하세요.
배달 음식도 리뷰와 사진 등을 참고해 신뢰할 수 있는 가게를 선택하세요.
(3) 정부와 업계의 노력
정부는 정기적으로 외식업체를 점검하고, 위반 업체에 대해 강력한 처벌을 시행해야 합니다.
업계는 위생 인증제를 활성화하여 소비자 신뢰를 강화해야 합니다.

■ 식품위생은 신뢰의 기본입니다 🍽️
이번 사건은 단순히 한 식당의 문제가 아니라, 소비자 신뢰와 건강을 저버린 심각한 위생 문제입니다. 😔
식품위생은 모든 외식업체가 지켜야 할 기본 중의 기본이며, 이를 어길 경우 소비자뿐 아니라 업계 전체에 악영향을 미칠 수 있습니다.
여러분은 이런 상황을 겪으셨다면 어떻게 대처하셨을 것 같으신가요?
의견을 댓글로 남겨주세요! 🙌
함께 건강하고 안전한 외식 문화를 만들어갑시다. 😊
#식품위생 #외식업문제 #위생논란 #음식점위생 #돈가스논란 #식품위생법 #외식문화 #위생교육 #소비자신뢰 #건강한식문화 #음식물쓰레기통 #위생문제해결 #음식점신고 #위생법위반 #식품안전 #외식업개선 #소비자보호 #식품위생교육 #식당점검 #건강한외식